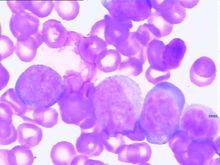
原發性中樞神經系統血管炎

概述
 原發性中樞神經系統血管炎
原發性中樞神經系統血管炎 原發性中樞神經系統血管炎是一種只局限侵犯中樞神經系統血管,而不累及其他系統的炎症性疾病。患者常僅有神經系統症狀的臨床表現,但神經定位又不很明確,腦脊液檢查、腦CT及MRI均不能明確診斷,給診斷和治療帶來很大困難,因而延誤診治,造成死亡等嚴重後果。中國報導很少。為引起對這種少見類型血管炎的重視,故此綜述如下。
PACNS的命名曾一度混亂,Cravio和Feigin於1959年首次屍檢報告本病並命名為肉芽腫性血管炎。其後發現肉芽腫是並非特異性表現。因其主要病變是累及中樞神經系統血管的炎症,1983年採用“孤立性中樞神經系統血管炎”(isolated angitis of the CNS,IACNS)的提法,但對有些有不同程度顱外血管炎症的病人,IACNS則顯得太局限,還有人根據其中樞血管病的病理不同再分為亞類型,稱中樞系統良性血管病。近年來多認為PACNS的命名更為合適,既表述了疾病的解剖部位,又表述了其主要的病理改變和病理類型。
臨床表現
 原發性中樞神經系統血管炎
原發性中樞神經系統血管炎 1.PACNS可發生於任何年齡既往身體多健康平均發病年齡在40多歲(3~74歲)男女均可發病男性略多約60%的患者呈急性或亞急性起病,但有些患者可呈緩慢進展的智慧型衰退,以及局灶性神經損害的病程在疾病的早期症狀可自行緩解。 2.最常見的症狀是頭痛據文獻報導其發生率約占58%。約80%的患者出現中樞神經系統損害的症狀與體徵,可表現為偏癱、下肢輕截癱、四肢癱偏身感覺障礙偏盲抽搐等局灶性腦部損害症狀;也可表現為精神症狀、人格變化、不同程度意識障礙甚至昏迷等多灶性、瀰漫性損害的症狀約1/3的患者出現腦神經損害的症狀,常見面神經和展神經損害,表現為周圍性面癱眼球運動障礙等。
3.少數患者可有脊髓損害的表現一般無發熱體重減輕關節痛等全身性症狀也無累及其他臟器的表現
併發症:意識障礙精神狀態改變智慧型障礙或甚至痴呆。
病情診斷
診斷:1.原發性中樞神經系統血管炎(PACNS)缺乏特徵性的臨床表現,臨床診斷PACNS比較困難但對具有頭痛、痴呆、精神狀態改變、局灶性神經損害的症狀與體徵脊髓病及腦神經病表現的患者,而又無法用其他的疾病來解釋時應高度懷疑PVCNS的診斷;2.腦血管造影及結合立體定向腦組織活檢對PACNS的確診有決定性價值。
鑑別診斷:在高度懷疑PACNS時,應與下列疾病鑑別如系統性血管炎(結節性多動脈炎過敏性血管炎顳動脈炎、白塞病結締組織病性血管炎等)感染(病毒性感染細菌性感染真菌性感染、立克次體感染等)、腫瘤(霍奇金淋巴瘤白血病小細胞性肺癌、心房黏液瘤非霍奇金淋巴瘤等)其他血管病(血小板減少性紫癜結節病、腦血管動脈粥樣硬化、鐮刀樣細胞性貧血等)及其他(壞死性類肉瘤樣肉芽腫變態反應性肉芽腫病、淋巴瘤樣肉芽腫病等)因其影響CNS的血管時臨床表現酷似於PACNS。
檢查方法
原發性中樞神經系統血管炎
原發性中樞神經系統血管炎 實驗室檢查:1.血、尿便常規檢查多正常;2.ESR大多正常,少數可增快無其他自身免疫性疾病的證據;3.腰穿CSF檢查80%的患者有異常,CSF壓力正常無色透明,細胞數可增高或正常,以淋巴細胞增多為主,糖和氯化物含量正常蛋白略增高。 其它輔助檢查:1.腦電圖檢查約81%的患者有異常多呈非特異性的瀰漫性慢波;2.腦CT或MRI檢查不同患者的表現差異很大。多數顯示有大小不等的低密度缺血病灶或梗死灶。可呈不對稱性強化。3.腦血管造影有一定的診斷價值71%以上的患者有典型的血管多灶性損害的表現,血管粗細不均,可呈節段性的狹窄或擴張血管阻塞及血管排空延遲等似“臘腸”樣改變,提示腦部血管炎的存在但不能明確是本病的血管炎其他的腦部繼發性血管炎也可有類似的表現有些可因受累的血管太小,腦血管造影可正常。
4.腦組織活檢對腦部病灶的立體定向手術活檢對PACNS的診斷有決定性意義活檢組織的病理可見軟腦膜小血管有節段性壞死或肉芽腫性血管炎。血管壁有明顯的炎症表現,常有淋巴細胞單核細胞、組織細胞及漿細胞的浸潤為了提高其診斷的準確率建議活檢時同時取材皮質和軟腦膜。
治療方法
1.目前對PACNS尚無特效療法。
2.類固醇激素和免疫抑制藥治療可有效改善症狀控制病情發展。常用藥物有潑尼松(潑的松)、甲潑尼龍(甲基強的松龍)、環磷醯胺、氮介類等可以靜脈或口服給藥。藥物用量同其他自身免疫性疾病。
3.可結合套用抗生素阿司匹林等藥物。
預防措施
預後:原發性中樞神經系統血管炎(PACNS)若不治療其病死率相當高可達90%以上,若單獨套用類固醇激素治療其病死率較不治療者降低了約50%,如套用類固醇激素和免疫抑制藥聯合治療,則其病死率降低至10%以下。因此早期診斷與早期治療對PACNS的預後非常重要。
預防:原發性中樞神經系統血管炎(PACNS)尚無較好預防措施,應早期診斷及早期治療在緩解期,激素維持量要服用數月,可改善預後。

